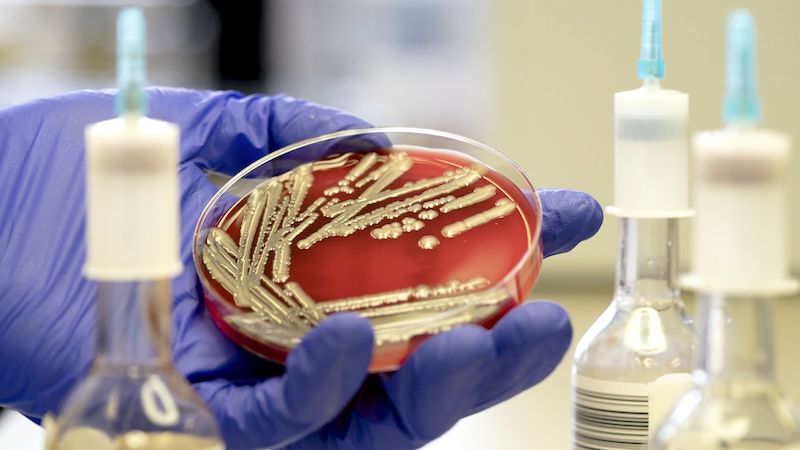
Des chercheurs creent une bactérie E Coli qui se nourrit de dioxyde de carbone

Pour ne plus être addict au smartphone, retirez-lui ses couleurs !
Pour réussir sa digital detox, un ex-employé de Google recommande de passer son téléphone en nuances de gris, un mode aujourd’hui proposé sur les nouveaux smartphones. Une façon efficace de mettre fin à l'effet addictif…
Avatar 2 : le tournage enfin terminé, les fans n’ont “plus que” deux ans à attendre
Après un an de retard sur son planning initial, la suite d’Avatar vient enfin d’achever son tournage. Mais seulement en prise de vues réelles, car il reste maintenant à attendre encore deux ans de post-production…

Téléphone au volant : l’Australie utilise l’IA pour traquer les contrevenants
Pour la première fois, un système de surveillance va utiliser l’intelligence artificielle pour reconnaître les conducteurs qui utilisent leur smartphone en conduisant.

TV connectées : le FBI lance un avertissement à propos de la sécurité des Smart TV
Le FBI profite du Black Friday pour mettre en garde les consommateurs contre les dangers des Smart TV. L’agence rappelle que ces appareils collectent des données personnelles, et qu’ils peuvent être piratés ou servir de…

Xpeng P7, un concurrent sérieux au Model 3 de Tesla en Chine
Fort du succès de son SUV G3, la marque chinoise Xpeng dévoile sa berline P7 au Salon de l’automobile de Guangzhou. Un véhicule électrique qui a fait forte impression, et qui dispose de tous les…

Star Wars 9 : pourquoi Leia porte-t-elle un sabre laser dans le dernier spot TV ?
Disney a dévoilé un nouveau spot TV de Star Wars : L’Ascension de Skywalker qui contient des images inédites. La scène la plus notable montre pour la première fois Leia en possession d’un sabre un…

PlayStation 5 : une vraie photo du devkit de la console fuite enfin
Double choc sur la DualShock : une photo sur Twitter révèle le design de deux devkits de la future console PS 5 de Sony qui devrait sortir en fin d’année prochaine.

Spider-Man sauve les Gardiens de la Galaxie dans une scène coupée d’Infinity War
Le coffret du MCU Infinity Saga révèle une scène supprimée où Peter Parker fait de son mieux pour protéger les Gardiens sur le champ de bataille de Titan.

Forfait Bouygues Sensation avec Avantages Smartphone : remise de 100 € sur les mobiles pendant le Black Friday
Jusqu'au 2 décembre, Bouygues célèbre à sa façon le Black Friday et le Cyber Monday, en vous proposant le code promo BLACKWEEK, qui vous procure une réduction immédiate de 100 €. Il suffit d'utiliser ce…
Des chercheurs créent une bactérie E. Coli qui se nourrit de dioxyde de carbone
Des scientifiques ont mis au point une souche de bactéries E. Coli qui pourrait notamment être utilisée pour créer des biocarburants moins polluants à produire.

Les câbles sous-marins d’Internet vont servir à détecter les séismes
Des chercheurs proposent d’utiliser les câbles de fibre optique sous-marins existants comme des séismographes. Les premiers résultats sont particulièrement encourageants.

Marvel : une fuite dévoile le vilain du MCU Phase 5
La phase 3 du Marvel Cinematic Universe avait mis en avant le puissant Thanos comme vilain charismatique des 2 épisodes d’Avengers, Infinity War et Endgame. Une fuite vient d’annoncer qui prendrait sa place dans la…

Star Wars : des objets rarissimes de la première trilogie mis aux enchères aujourd’hui
Une vente aux enchères exceptionnelle commence aujourd’hui avec des dizaines d’objets rares issus de la première trilogie Star Wars.

Spielberg ressuscite E.T. pour Noël, mais seulement pour quelques minutes
Près de 40 ans après la sortie du chef d’œuvre de Steven Spielberg, E.T. revient, mais seulement pour une publicité de 4 minutes. Le film met en scène une visite de l’extraterrestre à son ami…

Panne de toilettes dans l’ISS, les astronautes doivent porter des couches
Toutes les toilettes de la station spatiale internationale sont hors service. En attendant de trouver une solution, les astronautes de la station sont contraints de porter des couches ultra-absorbantes comme pendant leurs sorties extravéhiculaires ou…

Mars : La NASA observe une tempête de sable la taille de l’Europe
Si les tempêtes de sable sont relativement rares sur Mars, certaines peuvent être absolument gigantesques. Celle de l’année dernière a été observée par les astronomes de la NASA alors qu’elle mettait fin à la vie…

Red Dead Redemption 2 est enfin téléchargeable sur Steam
Red Dead Redemption 2 sera enfin disponible sur Steam le 5 décembre, un mois après ses débuts sur PC sur trois autres plateformes de diffusion.

La Reine des Neiges 2 : Elsa fait son coming-out dans une chanson, assurent les fans
Après Libérée, Délivrée, les fans sont à nouveau convaincus qu’Elsa est un personnage gay et que la chanson Je te cherche est un hymne LGBT.

Star Wars 9 : John Boyega avoue la fuite du script de L’Ascension de Skywalker
L'acteur qui joue Finn vient d’admettre sur la TV américaine que c’est bien son exemplaire du script du prochain Star Wars qui s’est retrouvé sur eBay pour environ 80 euros.

Windows 10 : comment lui redonner le look et les fonctions de Windows 7 ?
Windows 10 ne vous plaît pas ? Vous préfériez Windows 7 ? Voici toute une série de petits outils et d’astuces capables de redonner au dernier système d’exploitation de Microsoft son look et ses fonctionnalités…

L’ESA envisage de faire hiberner les astronautes pour les très longs trajets
Parmi les technologies clés pour effectuer des voyages de longue durée dans l’espace, l’ESA a identifié l’hibernation. Une équipe de scientifique a donc été chargée d’étudier ses impacts sur l’homme, mais aussi sur les systèmes…

Avengers Infinity Wars : et si Thor n’avait pas forgé Stormbreaker ? Marvel dévoile sa version alternative
Grâce au livre Avengers: Endgame - The Art of the Movie, les fans de Marvel ont découvert une version alternative de la quête de Stormbreaker. Dans celle-ci, Thor ne forge pas la hâche, mais doit…

Micro Machines : les petites voitures des 80’s et 90’s reviennent en 2020
Les trentenaires et les quarantenaires s’en souviennent à coup sûr, les Micro Machines, ces voitures miniatures plus petites que des Majorettes ou des Hot Wheels feront leur grand retour l’année prochaine.

Stadia : Google assure que le Chromecast Ultra ne surchauffe pas, malgré les plaintes
Le Chromecast Ultra n’a aucun problème de surchauffe, affirme les responsables de Google Stadia. Pourtant de nombreux utilisateurs se plaignent d’être régulièrement déconnectés de la plate-forme à cause d’une température anormale de la clé HDMI.

Tesla : la planche de bord du Cybertruck est en papier
Grâce à une vidéo prise durant la phase d’essai qui a suivi la présentation, nous apprenons que la planche de bord du Tesla Cybertruck est fait en papier. Le pick-up de Tesla ne finit pas…

Des scientifiques ont trouvé le moyen d’empêcher les IA de se rebeller
Skynet et HAL 9000 n’ont qu’à bien se tenir : des chercheurs américains ont conçu un algorithme qui garantit que l’intelligence artificielle ne nuira pas aux humains.

The Mandalorian est devenue la série la plus populaire du monde en seulement 10 jours
La série Star Wars The Mandalorian devient la série TV la plus populaire du monde avec 100 millions de requêtes et de téléchargements en une semaine.

Tom Cruise est trop vieux pour continuer à jouer Jack Reacher
Tom Cruise serait trop vieux pour jouer Jack Reacher, affirme Lee Child, l’auteur des romans de la saga. Selon ce dernier, il est temps que l’acteur de Mission Impossible cesse de tourner des films d’actions.

Stadia : Google explique pourquoi certains jeux n’atteignent pas 4k 60 FPS
Après un lancement raté, Google a dû faire face à de nombreuses critiques à propos de la qualité des jeux sur Stadia, bien en dessous des 4k 60 FPS annoncés. La firme réagit enfin pour…

Accusé d’espionnage, Huawei poursuit des journalistes français en diffamation
Malgré sa mise sur liste noire par les autorités américaines, Huawei dément formellement les accusations d’espionnage ou de collusion avec le pouvoir chinois. Au moment où les Européens doivent choisir les équipementiers pour déployer la…
